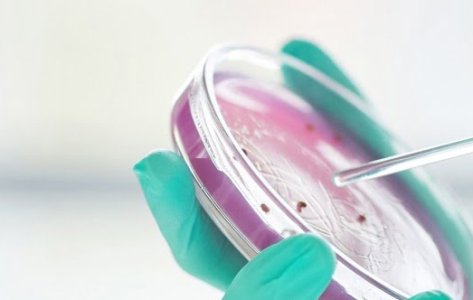
Antimicrobial vs Antibacterial

Dr. Sudha Ramkumar
About Author
Dr. Sudha Ramkumar holds a Ph.D. in Biotechnology with a specialization in drug discovery, focusing on small molecule inhibitors and the development of cell-based assays. She brings extensive expertise in drug screening and efficacy testing against various viral strains, with a strong emphasis on antimicrobial and antiviral efficacy evaluations. At Microbe Investigations Switzerland (MIS), Dr. Ramkumar serves as the Operations and Process Manager, overseeing the bacteriology and virology departments. In this role, she focuses on the efficacy testing of a wide array of products against bacterial, viral, and fungal strains. Beyond technical management, Dr. Ramkumar actively contributes to strategic business development, seamlessly integrating scientific research with client-focused solutions.
Research expertise and contributions
Dr. Sudha Ramkumar’s technical acumen encompasses diverse areas of biochemistry, molecular biology, and in silico drug design. She possesses a comprehensive skill set in biotechnology, including the bioactive screening of herbal extracts, isolation, characterization, and identification of the mode of action of antidiabetic drugs.
Dr. Ramkumar’s competence comprises the development of cell-based assays for screening of antiviral drugs. In addition, she is proficient in core molecular biology techniques such as cloning and RT-PCR, and her bioinformatics expertise encompasses enzyme-based docking and analyses in transcriptomics and metabolomics. Her adept use of state-of-the-art analytical techniques, including gas chromatography and high-performance liquid chromatography (HPLC), combined with her expertise in bioinformatics, underpins her major contributions to the fields of drug development, quality assurance, and innovations in diagnostics and therapies.
Product screening and efficacy assessments
Dr. Sudha Ramkumar has a profound expertise in the field of antimicrobial efficacy testing, conducting precise evaluations of antiviral drugs and products within BSL-3 laboratories, adhering to stringent GLP and ISO 17025 guidelines. Her proficiency with automated liquid handling systems, coupled with an in-depth understanding of international standards such as ISO, EN, ASTM, JIS, and EPA, ensures precise and reliable efficacy screening. This proficiency encompasses a broad range of products/chemistries, including disinfectants, surface coatings, textiles, and cosmetics, contributing to advancements in public health and product safety.
Featured Blogs
Key Takeaways Demonstrates that disinfectant
Disinfectants require approval from the
Antimicrobial textiles have recently gained
Subscribe to Our Newsletter
Ready to test your product?